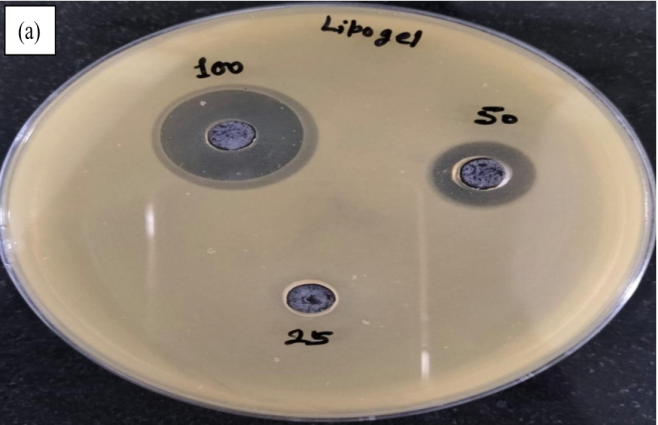
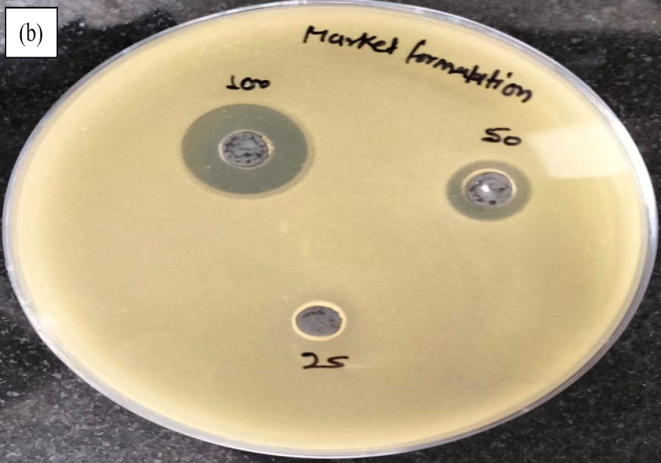

1Department of Pharmaceutical Sciences, Maharshi Dayanand University, Rohtak-124001, Haryana, India. 2Department of Pharmaceutical Sciences, Chaudhary Bansi Lal University, Bhiwani-127021, India
*Corresponding author: Deepak Kaushik; *Email: deepkaushik1977@gmail.com
Received: 21 Jan 2025, Revised and Accepted: 20 May 2025
ABSTRACT
Objective: The present research work was aimed to develop and design novel anti-acne herbal lipogel using extract of Ocimum tenuifloram (L.) leaves with ethanol injection method. It is the first time herbal lipogel containing liposomes that, improves the drug retention time and increases its therapeutic efficacy.
Methods: This research work included the preparation of liposome vesicles by Ethanol injection technique by using cholesterol, soya lecithin, ethanol and Ocimum tenuifloram Lamiaceae (L.) extract. The liposomal vesicles were optimized by Box Behken Design (BBD). The formulation of herbal lipogel of Ocimum tenuifloram (L.) extract shows maximum anti-bacterial results against Propionibacterium acne (p. acne) bacteria with 19.31 mm and 12.675 mm zone of inhibition when compared with marketed anti-acne formulation. The optimized size of liposomes with 198 nm was observed.
Results: By analysis of Gas chromatography-mass spectrometry (GC-MS) and High-performance liquid chromatography (HPLC) method, the presence of eugenol (32%) was determined. The optimized batch of liposome (F6) was selected with entrapment efficiency (EE%) 79.8% and zeta potential (ZP)-19.8mV.
Conclusion: Finally, it can be concluded that the prepared novel herbal lipogel of Ocimum tenuifloram (L.) extract was suitable in acne on the basis of in vivo studies. The optimized herbal lipogel formulation was safe and effective when compared with other marketed herbal formulations of acne.
Keywords: Ocimum tenuifloram (L.) herb, Liposomes, Antibacterial activity, In vivo studies, Stability studies
© 2025 The Authors. Published by Innovare Academic Sciences Pvt Ltd. This is an open access article under the CC BY license (https://creativecommons.org/licenses/by/4.0/)
DOI: https://dx.doi.org/10.22159/ijap.2025v17i4.53761 Journal homepage: https://innovareacademics.in/journals/index.php/ijap
The skin is suitable route for herbal products due to immense surface area. By applying on the skin, many anti-acne products are spread around the various layers of skin. Due to high rate of absorption of drugs by transdermal drug delivery system (TDDS), herbal formulations are used topically than oral route. It reduces the risk of side effects and minimizes the irritation of drugs into stomach. More than three decades ago, liposome preparations were used as topical skin products. Now, it has become a major part of the novel drug delivery system (NDDS). Liposomes are spherical vesicles which enclose several bi-layers of phospholipids with aqueous and non-aqueous layers or compartments. Liposomes are made up of two words; lipid means ‘fat’ and soma means ‘body’. The size ranges of liposomes are between 20 nm-10µm. There are several methods for preparation of liposomes like cold method, ethanol injection method, ether injection method and solvent evaporation method, but ethanol injection method provides liposomes with affordable size and lower in cost. It also easily permeable to skin barriers that present in epidermis. In ethanol injection process, removal of ethanol takes place from aqueous solution of liposomes and it results into encapsulation of drug material into liposomes. The liposomes particles with minimum size due to its subcellular size may rises the antibacterial activity of eugenol by enhancing into passive cellular absorption process and it also reduces mass transfer resistances. When applied on the skin optimized formulation was smooth and non-sticky [1, 2].
Chemicals like benzoyl peroxide and tretinoin have some complexity on the layers of skin into acne for patient’s inconvenience. All these non-herbal products available into the market have so many drawbacks it contains oil-based products such as anti-acne creams or ointments. This type of formulation work as counterproductive because it contributes and fights against acne by clogging the skin pores. Products like salicylic acid and benzoyl peroxide are more unbearable than acne. So, it is necessary to prepare water-based formulations with no adverse effects. To overcome the problem of bacterial resistance, herbal products need to be explored [3, 4].
On the basis of literature study, Ocimum tenuifloram Lamiaceae (L.) is an effective herb with anti-inflammatory and antibacterial properties against Propionibacterium acne (P. acne) bacteria. The leaves of Ocimum tenuifloram (L.) are easily available and efficacious herb with least side effects, other than synthetic formulations of acne. The extract of Ocimum tenuifloram (L.) is used as an ideal herb with anti-acne properties. It cures symptoms of acne like flaky skin, inflammation and redness by bacteriolysis of Propionibacterium acne. Ocimum tenuifloram (L.) plant extract helps to prevail over the problems of skin acne. The liposome formulations have strong binding capacity with metabolites present into plant extract [5-8]. Lipogel contains drug matrix in form of semisolid formulations. For prolongation of inflammation, P. acne bacteria play a vital role [9]. In sebaceous gland follicles, P. acne bacteria release proteases, lipases and hyaluronidases that damage skin tissues [10, 11].
The main component of the Ocimum tenuifloram (L.) plant is eugenol (4-allyl-2-methoxyphenol) that is volatile phenolic constituent [12]. Derivatives of eugenol are used into pharmaceutical field as an anesthetic and local antiseptic. Eugenol exhibits analgesic, anti-inflammatory and antimicrobial activity [13, 14]. Moreover, it causes intensification in penetration of drugs on skin. Eugenol is also used into inflammation of acne and other skin diseases. According to the Food and Drug Administration (FDA), eugenol is considered as a shield for acne-affected patients [15]. It is widely active against g–ve and g+ve bacteria. It increases vandalization of cell membrane in bacteria. The encapsulation of eugenol present into liposomes plays important role in physical stability and it protects eugenol from interaction with other constituents and decreases its volatility and enhances its bioactivity. It has been studied into the literature that the bioavailability of eugenol compound present into liposomes was bigger than other conventional liposome preparations [16-18].
The use of herbal lipogel preparations compared with market anti-acne preparations is high in demand for the treatment of acne. Ocimum tenuifloram plant extract used in acne treatment was found to be cost effective and efficacious with lesser side effects when compared with other synthetic formulations used for acne. In this research work we applied Box-Behnken Design (BBD) Design Expert software for optimization of liposome batches. It was used in this research to optimize and interaction of independent variables that might match with prerequisites of suitable dependent responses [19]. To determine the difference between quantitative variables, one-way Analysis of Variance (ANOVA) was followed and less than 0.05 p-values was observed as statistically significant. The BBD drug design was used for the selection and preparation of formulation with maximum desirability. The optimized values of various dependent responses should be close to predicted values. It also indicates the validation of drug design. The drug design BBD was applied between the responses and the variables to examine the interaction and optimization of independent variables. Therefore, the aim was to develop and optimize herbal lipogel by Ethanol injection method and then executed in vivo and in vitro studies [20].
Material
Ocimum tenuifloram (L.) herb was collected from the local garden of Safidon, Haryana (India). Soya lecithin (purity>97%), methanol (purity>99.9%), ethanol (purity>99.9%), triethanolamine (purity>99.7%), propylene glycol (purity>99.7%) were bought through Loba Chemie Laboratory reagents and fine chemicals Ltd, Mumbai, India. Cholesterol (purity>99.9%) was acquired from Sigma Aldrich. Carbopol 934 and 940 (purity>99.8%) were bought from Loba Chemie Pvt. Ltd. India. The bacterial strain of P. acne (MTCC No. 1951T) was bought from the Institute of Microbial Technology, Chandigarh (India).
Collection, authentication and extraction of Ocimum tenuifloram plant
Plant leaves with specimen number 9911 were procured from the herbal garden of Safidon, Haryana (India) and authenticated by the Department of Botany Maharshi Dayanand University (MDU), Rohtak by Dr. S. S. Yadav HOD (Head of the Department) on the date 22 May 2019. Leaves were collected and cleaned by using clean water. Dry it for one week and make powder from it by a mixer-grinder (Sujata Powematic Plus 900). Then, pass it through the sieve number 82 to obtain coarse powder. Twenty gs of plant leaves powder (1/3 of methanol) was macerated with 200 ml methanol. Shake it for 6 h on a rotary flask shaker (NYC Lab Instruments). Then, kept it for 18 h on room temperature and filtered with Whatmann filter paper to remove the solvent. Dry it for three to four days to evaporate the moisture and weighed the extract using weighing balance [21].
Pre-formulation study
1 % yield and pharmacognostical analysis of ocimum tenuifloram extract
The extract of leaves was dried to evaporate the moisture and weighed it. Then calculate the % yield by using following method. The evaluation of Pharmacognostical analysis of Ocimum tenuifloram extract was concluded on the basis of total ash value found was 8.7%, Loss of Drying (LOD) was 4.19%, acid‑insoluble ash was 0.91% and water‑soluble ash was 5.21%.
Percentage yield= Final weight of extract ×100/Initial weight of extract
Analytical methods for identification of eugenol in ocimum tenuifloram extract
There were various methods for identification of Eugenol in Ocimum tenuifloram extract as shown in table 1.
FT-IR (Fourier transform infra-red spectroscopy) analysis
The FT-IR analysis of herbal extract, soya lecithin, cholesterol and polymers were carried out by analyzing on a spectrum 400, spectrometer (Spectrum Two, Perkin Elmer, US). The spectra of IR were measured in the range of 4000-400 cm-1. FT-IR analysis was used for the structure analysis of extracts. The potassium bromide (KBr) disc analysis was used due to its no absorption property of KBr into fundamental region of the IR spectrum. During analysis of FT-IR, the sample of a drug/extract was kept under a modulated IR beam into a die and the sample was analyzed [27, 28]. Then, analyzed the resulting pattern of FT-IR spectra and matched it with known spectra of identified compounds.
Table 1: Analytical methods for identification of Eugenol
| S. No. | Analytical method | Model name | Function | Reference |
| 1. | UV (Ultraviolet-visible) –spectroscopy | UV-1800, Shimadzu, Japan | For the study of structural information of various categories of drugs/extracts, on the basis of chromophoric portion of the molecules into solution. A plot between absorbance v/s wavelength records as UV-spectrum and determined the λmax of eugenol in Ocimum tenuifloram plant extract | [22, 23] |
| 2. | HPLC (High-performance liquid chromatography) analysis | HPLC-Model 1260 Agilent Technologies, US | The HPLC was most popular analytical technique used to control the quality of plant products. HPLC method was developed and validated for quantitative analysis of eugenol in methanolic extract of Ocimum tenuifloram plant. Reverse phase chromatography was carried out in isocratic conditions with the help of the C-18 reverse phase column (5µm with 250×4.6 mm) internal diameter, Luna 5µm, 250×4.6 mm internal diameter, Luna 5µm C-18 (2); phenomenex | [24] |
| 3. | HPTLC (High-performance thin layer chromatography) analysis | HPTLC-Applicator AS 30,230V, Biostep GmbH, Germany | Samples of eugenol were applied into band form accompanied by thickness of 5 mm using µl** syringe, on an aluminum plate that was already plated with silica gel of 0.2 mm width. Then, by operating CAMAG TLC scanner 3, densito metric scanning takes place at 245 nm absorbance. | [25] |
| 4. | GC-MS (Gas chromatography-mass spectrometry) analysis | GCHS-FID-MS, Model 8890, Agilent Technologies, USA | GC-MS analysis was browned on a chromatograph of PerkinElmer 8500 gas chromatograph with FID detector and a capillary column with coated thickness of 30m×0.25 mm and 0.25 µm. GC-MS was operated at 60 °C with heat up to 220 °C at 4 °C/min for 5 min. Helium was used as carrier gas with flow rate, 2 ml/min with 1:40 split ratio; scan time, 1s; acquisition mass range, m/z 40-400; ionization energy, 70 eV; in GC-MS. Prepared samples were diluted into methanol with 0.2 µl and injected into less split mode | [26] |
Differential scanning calorimetry (DSC) analysis
Due to exothermic processes, it was possible to auto-oxidation of lipids, fats and fatty acids and by using thermal analysis methods like thermo-oxidation and thermo-stability. The DSC method was most useful method due to its milder conditions and short time utilized observation of samples with lipid formulation and volatile antioxidants composing the aqueous phase. In the range of 180 to 380-400 °C, an exothermic peak was observed that is related to the auto-oxidation process.
DSC equipment was composed of flow controller operating software, a calorimeter and a thermal analyzer. Samples of plant extract, polymers and other samples of herbal lipogel preparation were placed on the pan one by one and put inside the DSC instrument (DSC2-00347, TA instrument) and it started heating from 25-350 °C with rate of 50 °C/min into nitrogen environment [29, 30].
Partition coefficient
The Partition coefficient (oil/water) is the determination of the lipophilicity/hydrophilicity of a drug with an indication of the ability of the drug to move membranes of cells. Drugs having values of P higher than 1 and are known as lipophilic. On the other hand, those with values lower than 1 is indicative of a hydrophilic drug. It is commonly calculated by water and an oil phase of n-octanol. In the calculation of n-octanol and water: P o/w = C n-octanol/C water
It is a coefficient of two concentrations of drug in water (C water) and n-octanol (C n-octanol), respectively and defined in the form of its logarithm to base 10 (log P). It was done using shake flask method. Excess amounts (100 mg) of the plant extract was dissolved into solvents (n-octanol: Water) similarly (1:1) and kept it for 24 h. After 24 h, the layers were removed separately and centrifuged for 15 min. Then, absorbance was measured on a UV spectrophotometer at λ max 281 [31].
Preparation of liposomes using ethanol injection method
For the preparation of liposomes, an ethanol injection technique was applied. It involves the liposome preparation of the lipid phase into an aqueous phase with continuous stirring on magnetic stirrer (RCT Basic, IKA, Germany) by using a syringe. Soya lecithin and cholesterol were mixed into ethanol and added into plant extract containing water solution on magnetic stirrer by using at 500 rpm and room temperature with slight heating for half an hour. Various ratios of soya lecithin and cholesterol were used in ethanol and added slowly into aqueous solution of Ocimum tenuifloram extract with fine stream of injection [32].
Optimization of liposomal formulation with BBD
For optimization of liposomal formulation, a box-behnken design was implemented on Design Expert ® (Version 10, Stat-Ease Inc. Minneapolis, MN) software. Liposomes containing Ocimum tenuifloram were formulated using ethanol injection method. A three-level and three-factor Box-Behnken Design, was applied with Design Experts software that suggested 17 experimental runs [33]. Seventeen formulations of herbal liposomes of Ocimum tenuifloram were developed where on the basis of literature. There were three independent factors were fixed, namely, the soya lecithin (X1), cholesterol (X2) and ethanol (X3) as showed in table 2.
Table 2: Independent variable levels
| Factor | Name | Minimum | Maximum | Mean |
| A | Soya lecithin (w/w) | 1.0000 | 4.00 | 2.50 |
| B | Cholesterol (w/w) | 1.0000 | 2.0000 | 1.50 |
| C | Ethanol (v/v) | 5.00 | 10.00 | 7.50 |
All these factors were selected in different ratios, with the total concentration that equals to 100 %. All these factors were fixed with regard on the basis of optimized formulation that was specially design for topical use. The dependent responses particle size (Y1), entrapment efficiency (Y2) and zeta potential (Y3) plays important role into absorption and diffusion of drug compounds into the site of application. The liposome particle with lesser size of particle, highest entrapment efficiency and maximum zeta potential was suitable as optimized batch for topical lipogel formulations.
By using carbopol 940 with different concentrations, a gel base was prepared. The carbopol 940 with different concentrations (1%, 2%) was mixed into distilled water and kept it overnight. Then the hydrated polymer was diluted and optimized liposome formulations were added into it by stirring at 500 rotation per minute (rpm). Then, with the help of tri-ethanolamine, the pH of herbal lipogel was adjusted. After some time, add some excipients like 15% w/v polyethylene glycol (PEG-400), 0.5% w/v triethanolamine, 0.5% methylparaben and 0.5% propylparaben for the purpose of preservation. The penetration enhancers increased its penetration properties on skin [34].
Particle size and zeta potential
Particle size distribution is the percentage of particles into a certain size. These are also known as fractions or size classes. By calculated the particle size distribution, visualization of liposome vesicles at a specific size was examined. The zeta potential and vesicle size of the liposomes were optimized by using its suspension on Dynamic light scattering (DLS). It was mixed into millipore water and the whole program was set at an angle of 90°. The size of particles in liposome preparation was determined using Polydispersity index (PDI), which denotes the thickness of particle size. It also determines zeta potential. All formulations were observed by particle size analyzer instrument (Litesizer, Anton Paar, Austria) into different batches [35].
Entrapment efficiency
Entrapment efficiency of liposomes was calculated by the amount of entrapped extract. Liposomes made from lipids with long acyl chains showed enhanced drug loading, encapsulation efficiency and drug retention. Similarly, liposomes made from lipids with high degree of unsaturation and low superconductivity exhibited faster drug release rates. Additionally, increasing the amount of cholesterol in the liposome bilayer improved polydispersity index, decreased drug incorporation and accelerated drug release but had negligible impact on liposome size and ZP. Furthermore, encapsulating the drug in the liposome core enabled sustained drug release. The total quantity of extract was calculated after disrupting and dissolving the extract loaded liposome particles into methanol using bath sonicator for 15 min. Then, samples of liposomes were centrifuged (CPR-30 Plus, Remi Scientific Instruments, Mumbai) for 30 min at 10,000 rpm. Then, the free extract present in liposomes was calculated using supernatant at 281 nm on UV-visible spectrophotometer [36, 37].
Entrapment efficiency (%) = amount of free drug/total amount of drug × 100
Evaluation of prepared Ocimum tenuifloram lipogel
pH
By using a digital pH meter (OHPL-OP-024, Ohaaus, USA), the pH of gel formulation was determined. Weighed one g herbal lipogel formulation and dissolved it into 100 ml of de-mineralized water, then stored it for one hour. Then, note down the pH of the formulation in triplicate. Before performing this experiment, the device was calibrated using a standard solution of buffer with pH 6.4. The acceptable range of pH should be between 6 to7 because it is mildly acidic and causes no irritation on skin [38].
Extrudability, spreadability and viscosity measurement
For extrudability studies, prepared herbal lipogel was filled into a collapsible tube, which was already closed with a 20 g quantity of lipogel into it and then squeezed it gently. By the help of clamps, there was prevention of the rollback of the tube. Then, the closure of tube was removed and applied pressure, gel was extruded [39].
The Spreadibilty describes the area of application in which a gel spreads on the infected acne skin. The efficiency of gel’s bioavailability depends upon the spreading value of gel formulation. The value of spreadability was measured with the help of two different slides: a slip-off gel formulation that was spread through two slides and kept load on it. If the time consumed during separation of slides was less, then it showed better spreadability. The sets of two glass slides were used as standard dimensions. The lipogel formulation of herb was kept on the single side of the slide, than the other side of the second slide was placed on it. After this, a sandwiched-type dimension was formed into an area covered by length of 7.5 cm on slide. Then, the weight of 100 g was kept on the upper portion of the slide, so the herbal lipogel was completely spreaded between two layers of slide. Then, the weight was kept aside and the excess portion of herbal lipogel was scraped off from the slides. Without disturbing the slides, the upper slide was removed slightly and free from the tight weight of 100 g. Then, the 10 g weight was kept on the above portion of the slide carefully. The time consumed by the upper layer flowed 7.5 cm in distance and kept aside by the lower portion of slide, then the weight was recorded. Same experiment was performed thrice and then the average time was calculated. Then, spreadability was observed by the following formula [40]:
S’M× L/T
Where S denotes liposomal gel spreadability, M for weight kept on the upper slide (100g), l denotes the slide’s length (7.5 cm) and T was used for time utilized by the upper slide to roll down.
By using Viscometer (Visco QC 100, Anton Paar), herbal lipogel’s viscosity was measured. It was measured at room temperature at various rpm on rotating spindle S96. The herbal gel formulation with liposomes was poured into a beaker and dipped spindle into it. At different intervals, reading was calculated in upper case, middle case and lower case. The ideal viscosity of gel should be less than 4000 cps due to more accurate administration on skin [41].
Scanning electron microscopy (SEM)
On the basis of appearance of liposomes, the size was observed using SEM (JSM 6100, Jeol, Ltd. Japan) microscopy. The appearance of liposomes influences its drug distribution, targeting efficiency and surface ratio. The liposomes were observed under 4.0K and 2.0K magnifications to observe the shape of sphere and size distribution of liposome particles.
Transmission electron microscope (TEM)
In TEM instrument, an electron beam was used to form high-resolution images of the object with its internal structure on nanoscale. It is highly used in the material science, nanotechnology and microbiology industries. The prepared liposome of plant extract examined by TEM (JEM-F200, JEOL, New Delhi) [42].
Particle size of liposome-loaded hydrogels
The particle size of liposomes plays a vital role in its stability, biological distribution, release profile and cellular uptake. The polydispersity index (PDI) of liposome vesicles may affect its stability and particle size distribution. The value of PDI ranges from 0-1.0 in the case of liposome particles. The smaller the size of liposome particles, the higher the area of the surface and there was a strong interaction between the components derived from agglomeration-aggregation [43].
Zeta potential (ZP) of liposome-loaded hydrogels
By measuring the zeta potential, we can easily find out the surface charge of particle colloidal systems and repulsion energies between particles that affects its physical stability. After increasing the stability of liposomes, there was an increase in repulsion of particles. If the value of ZP lowers, then it means in order minimizing the energy of liposome particles and the aggregation of mixture forms attraction overcomes repulsion. Acceptable values of zeta potential were considered between lower than-30mV and higher than+30mV. This range was suitable for colloidal stability of liposomes. The liposome formulation loaded with plant extract represents zeta potential values was in the range of-22±0.46 mV [44-46].
In vitro release studies
By taking Franz diffusion assembly (J-FDC-07, Orchid Scientific, Maharashtra), in vitro drug release studies was observed. Use a membrane of cellulose acetate that was already soaked for 24 h into buffer of phosphate with pH 6.8 before the experiment. The membrane was tied between the receptor and the donor compartment. The compartment of receptor part was full of phosphate buffer containing 6.8 pH and 10 ml in quantity. Then, mixed the samples by magnetic stirrer and 1 ml samples were collected at predetermined time intervals and it was replaced with another buffer sample. Then, UV-spectroscopy was analyzed for study at 281 nm [47].
Drug release kinetics
Different mathematical models are used as a base to compare release profile and predict release mechanism. For drug release kinetics of optimized herbal lipogel, log cumulative percent drug remaining vs. time (first order), cumulative percent drug release vs time (zero order), log of % cumulative release vs. log time (Korsmeyer and Peppas Exponential Equation) and cumulative per cent drug release vs square root of time (Higuchi plot) were plotted. Then calculate the value of R2from the graph. Considering the determination coefficients, Higuchi model was found to fit in release data best. The best fit model for drug release kinetics was confirmed by the value of correlation coefficient near to 1 [48, 49].
Anti-microbial studies
By increasing the uses of allopathic drugs, different microorganisms attain resistance against various antibiotics, which leads to downfall in purchasing of conventional medicines. That’s why some new anti-acne herbal formulations have become important. According to the literature review, the plants of the ‘Lamiaceae’ family are best choice against acne [50].
Anti-bacterial assay
The extract of Ocimum tenuifloram showed an antimicrobial activity against g positive P. acne bacteria and it was evaluated by ZOI (zone of inhibition). The crude extract of Ocimum tenuifloram showed powerful anti-microbial activity at higher concentration when compared to its extract, herbal lipogel formulation and market formulation as standard. The range of inhibitory affects from strong to no inhibition by P. acne. All samples showed antagonistic effects against P. acne strains and exhibit decreasing antibacterial activity. The herbal lipogel formulation gave better antibacterial potential than others [51-55].
In vivo anti-acne studies (Skin irritation test)
The Wistar rats (24) with 200-250 g weight were procured from an animal house, Lala Lajpat Rai University of Veterinary Animal Sciences (LLRUVAS) Hisar (Reg No. 1669/GO/abc/12/CPCSEA). Wistar rats were maintained and kept into Central Animal House, MDU, Rohtak. All experiments related to animal work were performed using following International guidelines (US, 1989) and IPA by Animal Ethical Committee of Committee for the purpose of control and supervision of experiments on animals (CPCSEA), New Delhi, approved by Institutional Animal Ethics Committee (IEAC) with serial number 1767/RES/14CPCSEA. Wistar rats in free access to rodent water and diet kept into rat cages and stay them all at 22-23 °C temperature with 24h dark-light cycle. At the starting time of the studies, Wistar rats were acclimatized to the environment and experimented for few days [56].
Animals were distributed into four groups (each group with 250 mg gel): control group, plain gel group, herbal lipogel group and marketed gel (Neem-Tulsi gel by Good vibes) formulation group. Each group contained six rats in it. The wistar rats were anesthetized by intramuscular injection of ketamine 6 mg per kilogram of body weight and xylazine 1 mg per kilogram. The wistar rats were shaved by using surgical blades. After 1 h, 1 × 105 colony forming unit (CFU)/ml of suspension of P. acne bacteria was injected subcutaneously. After 24h, signs of irritation and redness were evaluated. The tendency of the formulation was observed based upon parameters like redness with inflammation.
Optimized herbal lipogel was spreaded on the upper layer of Wistar rat’s skin and applied into uniform direction over an area of 3 cm2. Then, observed the surface of skin until any change was visible like redness (erythema) after 3, 6, 12, 24h of application. Then, calculate the mean score of erythema depending upon its appearance. The values are no erythema with 0 score, slight erythema with 2 score, moderate erythema with 3 score and severe one with 4 [57, 58].
Stability studies
Stability study is the process of investigating drug loss from the liposomes and affects its stability during the storage period. An optimized batch of herbal liposomes was stored as per accelerated stability studies according to International Council for Hormonisation (ICH) in a stability chamber (NLHC 1631, Newtronic, Mumbai). The optimized batch of herbal lipogel was kept into a vial and stored in a refrigerator (4±2 °C), control conditions (25±2 °C/60±5% RH), and 40±2 °C/75±5% RH for 6 mo away from direct light. After a few days of interval, 1–6 mo, herbal extract present into liposomes was centrifuged and evaluated by its pH, entrapment efficiency, cumulative drug release, spreadability and viscosity [59].
Pre-formulation study
% yield of Ocimum tenuifloram extract
The % yield of extract was found to be 16.75±0.05% w/w yield.
UV-Analysis of Ocimum tenuifloram extract
The λ max was found to be 281 nm that was performed in triplicates and mark the conc. of eugenol sample. By using a calibration curve, the quantity of Eugenol was found 3.2 mg in 10 mg of plant extract [60].
HPLC fingerprinting analysis of Ocimum tenuifloram extract
It is a chromatographic technique used to develop a reversed phase column by using UV detection at 254 nm; in which methanol with HPLC grade was used as mobile phase and resolved at 8 and 9 peaks from the extract. HPLC method was developed for determination of eugenol into plant extract compared with standard sample of eugenol. Limit of detection (LOD) and limit of quantification (LOQ) of developed method was analyzed on lower concentration of eugenol by using blank methanol that was LOD 0.04 µg/ml, LOQ was 0.3 with linearity from 0.2-10.0 µg/ml and correlation coefficient was 0.996. The correlation coefficient plot of calibration curve resulted into good linear relation between concentration and area of curve. The values of % standard deviation for intra-day, inter-day and instrumental precision was less than 2% of standard which concluded that method was found precise. No other phyto-constituents were interfering during this process. The range of linearity for eugenol was determined by 10-100 µg/ml. the value of R2(correlation coefficient) was 0.997 for eugenol sample and on-line linearity (LOl) was 99.82%. The precision values were observed by variability of inter-day and intra-day. It was in the range of 0.00-0.27%. The inter-day precision values were observed for three days with each concentration and observed range of results were 0.15-0.41%. The recovery was calculated by putting the sample of eugenol with different standard solution of eugenol. The average recovery was found to be 96.21% for eugenol, it also defends reproducibility and reliability of method [61].
By using fingerprint profiles of extracted material, it was easy to identify the compounds present in plant species. HPLC fingerprinting of Ocimum tenuifloram extract showed major peaks at different retention times (min.) at wavelength 254 nm [62]. On the basis of HPLC analysis, the range of Eugenol into Ocimum tenuifloram plant extract was found to be 32.81% by mass with retention time 7.873 as shown in fig. 1.

Fig. 1: HPLC spectra of Ocimum tenuifloram plant extract

Fig. 2: HPTLC chromatogram of Ocimum tenuifloram plant extract
HPTLC
The extension of Thin Layer Chromatography (TLC) is known as HPTLC. It offers simplicity, efficiency, robustness and speed in analysis of plant extract into a quantitative manner. It enhances the resolution of constituents present in plant extract for its quantitative studies. The HPTLC chromatogram shows qualitative studies of standard Eugenol with plant extract as in fig. 2 [63, 64].
GC-MS analysis
On the basis of retention time, the mass spectra on VF-5 capillary column compared with standard and identified the compounds. On the basis of qualitative analysis, by GC-MS analysis, some other chemical compounds also found rather than eugenol into Ocimum tenuifloram extract, like 4-Acetoxy-3-methoxystyrene, 1,5-Cyclodecadiene, 1,5-Dimethyl-8-(1-methyl ethenyl), Vanillin, Bicyclononane, 2-Methyl-4,8,8-trimethyl-4-vinyl, Alpha-guaniene. There were various chemicals present into extract of Ocimum tenuifloram and eugenol was also found with retention time of 6.381 in extract as shown in fig. 3 [65].
Fourier transform infrared spectroscopy (FTIR)
The analysis of liposomes containing extracts of Ocimum tenuifloram, cholesterol, soya lecithin by FTIR. By using FT-IR spectra of plant extract and standard sample of eugenol, it was observed that there was presence of phenolic groups, alkanes, alkenes, alkynes, carboxylic groups, and ketogenic groups. For the identification of effective encapsulation of extract containing eugenol present into herbal lipogel, the analysis of the sample took place by FTIR. The spectra analysis of cholesterol, soya lecithin, extract and Ocimum tenuifloram extract containing loaded herbal liposomes by FTIR was visible in fig. 4.

Fig. 3: GC-MS chromatogram of eugenol in Ocimum tenuifloram plant extract

Fig. 4: Overlay of FT-IR spectrogram of Ocimum tenuifloram plant extract, soya lecithin, cholesterol, carbopol, physical mixture, optimized liposome formulation and optimized herbal lipogel formulation
The spectra analysis of soya lecithin showed peaks of 1698 cm-1 and 3409 cm-1, which refers to C=C and O-H stretching. Vibrational peaks at 1062 cm-1 and 1170 cm-1 with the presence of C-C bonds and C-O bonds observed in the molecule. The spectrum analysis of cholesterol (CH) denoted a broad peak at 3412 cm-1, which co-relates with stretching frequency between frequencies. On the other hand, strong frequency bands of between 3000-2800 cm-1, which was due to symmetric and asymmetric stretching frequencies and CH3 groups. Due to asymmetric stretching, there was a strong band at 1464 cm-1, while on the other hand, the peak at 1375 cm-1 showed asymmetric stretching that corresponds to the bending frequencies of CH3 and CH2 groups. Due to stretching of C-O, there was a peak shown at 1056 cm-1 in cholesterol molecules. There was a peak at 3468 cm-1 that showed FTIR spectra of eugenol-containing plant extract, due to O-H stretching. The presence of the C=C group in plant extract showed a characteristic band at 1638 cm-1. With stretching vibrations of CH3 and CH2, there were sharp peaks at 1367 cm-1 and 1432 cm-1. With C-O stretching vibration, peaks showed at 1034 cm-1. The peak was shown at 3458 cm-1 due to the presence of eugenol-containing extract-based liposomes and shows O-H stretching frequency and peaks at 2855 cm-1and 2928 cm-1, related with vibration of CH2 and CH3. In liposomes containing plant extract, the peak was observed for the C=C group at 1638 cm-1 and shifted to upper vibrations and showed in the 1645 cm-1 group. On the other hand, in broad peaks, it showed at 1377 cm-1 and 1463 cm-1 with vibrations of CH3 and CH2 groups in the eugenol presence into liposome vesicles. Due to the C-O vibration frequency, the peak was at 1055 cm-1. There was a slight shift and change in the vibrational frequencies due to electrostatic interaction between the extract from the plant and the extract of loaded liposome particles. The results of FTIR showed that there was the presence of an extract of eugenol in liposome vesicles [66].
Differential scanning calorimetry (DSC) analysis
On the basis of a study, we found that liposomes with plant extracts were more stable than its free form. On observation, we found that lipophilic substances into extract and lipids were packed tightly and regularly, extracting membrane permeability and conferring rigidity of membrane. The DSC thermogram was shown in fig. 5. Formulation containing liposomes showed peak at 119.24 °C, pure extract and the other at 132.71 °C. The obtained results show that the melting point of liposomes was higher than 40 °C, a property which was known as a prerequisite for topical formulation containing lipids [67].

Fig. 5: Overlay of DSC Thermogram of plant extract, cholesterol, carbopol, soya lecithin, physical mixture and optimized herbal lipogel formulation
Partition coefficient
The partition coefficient of Plant Extract in n-Octanol: Water was 0.0794. It defines that the plant extract was hydrophilic in nature.
Development of liposomes
As we know, soya lecithin is made up of different units of lipid compounds which work as a base for liposome particles and affect its stability. On the other side cholesterol gives strength to liposome compounds due to presence of tetracyclic moieties affect the size of liposomes. The ethanol used in liposome formulations enhances its rate of penetration of drugs into skin. It gives better entrapment efficacy and applicable size of liposomes with best zeta potential. By using BBD drug design, the effect of independent variables on entrapment efficiency, particle size and zeta potential were optimized. The BBD drug design projected 17 runs, and the observed responses were given in table 3.
Table 3: BBD drug design of Ocimum tenuifloram extract using ethanol injection method (n=3)
| Formulation code | A: Soya lecithin (w/w) |
B: Cholesterol (w/w) |
C: Ethanol (v/v) |
Particle size (nm) |
Entrapment efficiency (%) | Zeta potential (mV) |
| F-1 | 1 | -1 | 1 | 267±1.52 | 71.4±0.02 | -23.8±0.32 |
| F-2 | 0 | -1 | 1 | 287.4±1.21 | 54.7±0.99 | -23.8±0.51 |
| F-3 | 1 | 1 | 0 | 216±1.11 | 54±0.52 | -19.9±0.59 |
| F-4 | -1 | -1 | -1 | 254.3±1.34 | 63.2±0.85 | -20.8±0.66 |
| F-5 | -1 | 0 | 0 | 272.8±1.61 | 56.6±0.66 | -20.9±0.22 |
| F-6 | 1 | 0 | 1 | 255±1.66 | 73.43±0.02 | -22±0.86 |
| F-7 | 0 | 0 | 0 | 246±1.44 | 57±0.61 | -21±0.11 |
| F-8 | -1 | 0 | 1 | 293±1.26 | 55.85±0.39 | -22.3±0.46 |
| F-9 | -1 | 0 | 0 | 276.1±1.13 | 56.6±0.21 | -21.4±0.33 |
| F-10 | -1 | 1 | 0 | 257.8±1.61 | 44.71±0.41 | -19.3±0.51 |
| F-11 | 0 | 1 | 1 | 262±1.72 | 58±0.43 | -21.4±0.65 |
| F-12 | 0 | 1 | -1 | 206±1.34 | 67.4±0.91 | -18.4±0.51 |
| F-13 | 0 | 0 | 0 | 245±1.17 | 57.8±0.55 | -21.4±0.28 |
| F-14 | 0 | 0 | 0 | 246±1.32 | 57.8±0.54 | -21±0.44 |
| F-15 | 0 | 0 | 0 | 245±1.21 | 57.8±0.34 | -21±0.59 |
| F-16 | 1 | 0 | -1 | 198.77±1.33 | 79.8±0.15 | -19.8±0.88 |
| F-17 | -1 | 0 | -1 | 236±1.49 | 79.49±0.16 | -19.6±0.91 |
The size of liposome particles in all trial formulation batches was found to be 198 nm to 293 nm. The observed entrapment efficiency was 44.71% to 79.8% and zeta potential was-18.4mV to-23.8mV. All the obtained results were examined on the basis of individual responses [68]. On the basis of the fit summary of adjusted, predicted response and a sequential sum of squares; different models of response were selected as shown in table 4 and 5.
Table 4: Summary fit values for different responses
| Source | Particle size (Adjusted R2) |
(Predicted R2) | Entrapment efficiency (Adjusted R2) |
(Predicted R2) | Zeta potential (Adjusted R2) |
(Predicted R2) |
| Linear | 0.9848 | 0.9810 | 0.1884 | -0.1653 | 0.9698 | 0.9585 |
| Quadratic | 0.9804 | 0.9650 | 0.1564 | -2.0861 | 0.9661 | 0.9274 |
| Special Cubic | 0.9845 | 0.8824 | 0.9738 | 0.8298 | 0.9560 | 0.7555 |
| Cubic | 0.9976 | 0.9987 | 0.9703 |
![]() |
![]() |
| a | b |
![]() |
![]() |
| c | d |
![]() |
![]() |
| e | f |
![]() |
![]() |
| g | h |
![]() |
![]() |
| i | j |
Fig. 6: (a) 3D graph indicating the effects of variables on Particle size (b) contour plot for particle size (c) predicted v/s actual plot for particle size on liposomes of Ocimum tenuifloram plant extract (d) 3D graph indicating the effects of variables onentrapment efficiency (%), (e) contour plot for entrapment efficiency (%), (f) predicted v/s actual plot for entrapment efficiency (%) on liposomes of Ocimum tenuifloram plant extract, (g) 3D graph indicating the effects of variables on zeta potential, (h) contour plot for zeta potential and (i) predicted v/s acutal plot for zeta potential on liposomes of Ocimum tenuifloram plant extract (j) Desirability Index of Ocimum tenuifloram plant extract of particle size (nm), EE (%), zeta potential (mV)
Table 5: Results of ANOVA in three responses
| Term | Particle size | Entrapment efficiency | Zeta potential | |||
| (F-value) | (p-value) | (F-value) | (p-value) | (F-value) | (p-value) | |
| Model | 134.64 | <0.0001 | 67.11 | <0.0001 | 76.96 | <0.0001 |
| Linear mixture | 10833.68 | <0.0001 | 1457.58 | <0.0001 | 32.30 | <0.0001 |
| A(Soya lecithin) | 269.62 | <0.0001 | 65.84 | <0.0001 | 0.43 | 0.5260 |
| B (Cholesterol) | 61.64 | <0.0001 | 8.03 | 0.252 | 141.09 | <0.0001 |
| C (Ethanol) | 420.72 | <0.0001 | 39.96 | 0.0004 | 189.14 | <0.0001 |
| AB (A to B) | 0.052 | 0.8239 | 0.76 | 0.4129 | 0.32 | 0.5859 |
| AC (A to C) | 0.022 | 0.8854 | 106.55 | <0.0001 | 1.13 | 0.3122 |
| BC (B to C) | 0.03 | 0.9678 | 2.85 | 0.1350 | 0.015 | 0.9051 |
In Response 1, 2, 3 both the p-value and variable equations were utilized to find out the true variable effects on responses as shown in fig. 6.
It was considered as statistically significant with p-values of<0.0001. If the value of p was greater than 0.0001, then it indicates the terms used in the model were not significant. Later, analysis of variance (ANOVA) results revealed that the relationship between variables and responses came at a 95% level of confidence. On the basis of ANOVA, the results of response 1 showed significant effect on a linear mixture with p<0.0001 between soya lecithin and various factors.
Effect of variables on particle size
Vesicle size and particle size distribution were important parameters that kept into mind during the formulation of liposomes. According to research studies, it was noticed that the distribution of size and particle size of liposomes also affect the in vivo and ex-vivo studies. Hence, for the effective rate of drug delivery, the formulation should be of optimum size with a homogenous population. The ethanol injection method was used to produce liposomes that have a narrow size distribution. It can be concluded that the relative amount of soya lecithin, cholesterol and ethanol plays a major role in size and preparation of vesicles [69].
Final equation with coded values: Particle size (Y1) =+247.33-21.51 X1-12.21 X2+28.20 X3+0.52 X1 X2+0.24 X1 X3-0.085 X2 X3
Effect of variables on % entrapment efficiency
% Entrapment efficiency was an important parameter in liposome preparation because it affects the release rate of drugs and deposition of skin. There was a positive correlation observed between both variables X1, X2 and X3. Because of a rise in the amount of soya lecithin, cholesterol and ethanol, the effect of %EE also rises. From all the observed batches, the formulation with minimum size and intermediate % EE was selected as optimized formulation for herbal lipogel. Liposomes with small size can easily penetrate the surface of the skin than the larger ones.
Final equation with coded values:
Entrapment efficiency (Y2) =+57.92+4.58 X1+2.05 X2-3.75 X3-0.85 X1 X2+7.67 X1 X3-1.52 X2 X3+1.66X1 2-11.30 X2 2+13.06 X3 2
Effect of variables on zeta potential
The charge that develops between the liquid medium and solid surface is called zeta potential. The stability of Liposomes was directly affected by zeta potential. If the number of zeta potential was higher, the stability of liposomes was also greater. It also directly affects the aggregation rate of liposome suspension. Liposomes with zeta potential<-30mV and>+30 mV were considered more stable [70-75].
Final equation with coded values:
Zeta potential (Y3) =-21.07+0.062X1+1.33-1.37 X3-0.092 X1 X2+0.13 X1 X3+0.018 X2 X3
On the basis of desirability index and Coded equations, the F16 formulation was found to be an optimized formulation that has high value of entrapment efficiency with lesser size of particles. As we studied in literature part, formulation batch with improved Entrapment efficiency could enhanced the solubilization of extract material at elevated temperature. It also helps to enhance permeation rate of extract. Particle size of liposomes also affects the absorption efficiency. It increases bioavailability of extract. Larger the amount of drug encapsulated higher the rate of its bioavailability. Liposomes with large size have low rate of bioavailability than smaller ones.
Preparation of herbal lipogel
Weighed carbopol 940 (1%, 2%) powder and soaked it into water for one hour. After, the swelling of carbon stirred on a magnetic stirrer to dissolve the complete carbon molecules into distilled water. Then, an optimized formulation of liposomes (F16) with an extract of Ocimum tenuifloram was mixed into carbopol solution with mild stirring till the formation of lipogel. Then, with the help of tri-ethanolamine, the pH of herbal lipogel was adjusted. Then, add some penetration enhancers to raise its penetration properties on skin. After some time, add excipients like 15% w/v polyethylene glycol (PEG-400), 0.5% w/v triethanolamine, 0.03% methylparaben and 0.03% propylparaben for the purpose of preservation as given in table 6.
Table 6: Composition of herbal lipogel formulations C1F16 and C2F16
| Ingredients % | C1F16 | C2F16 |
| Carbopol 940 (w/w) | 1 | 2 |
| Propylene glycol (v/v) | 15 | 15 |
| Methyl paraben(w/w) | 0.15 | 0.15 |
| Propyl paraben (w/w) | 0.03 | 0.03 |
| Triethanolamine | q. s. | q. s. |
| Distilled water q. s (v/v) | 100 | 100 |
| Liposomal solution containing extract (v/v) | 5 | 5 |
On the basis of Desirability Index and coded equations, C1F16 was found to be optimized formulation and it was used for further other evaluation parameters as shown in table 7 [76, 77].
Table 7: Evaluation of herbal lipogel formulations C1F16 and C2F16 (n=3)
| Formulation | Color | Transparency | pH | Drug content (%) | Viscosity |
| C1F16 | Green | Transparent | 6.2 | 83.594±0.781 | 2914.67 |
| C2F16 | Green | Transparent | 6.3 | 81.203±0.781 | 2912.00 |
Evaluation of herbal lipogel
On the basis of visual inspection; color, consistency, pH, homogeneity and spreadability of herbal lipogel were determined with the help of a clarity chamber with a white and black background. The herbal lipogel was optimized on the basis of a physical examination. The color of herbal lipogel was green, with no coarse particles observed [78].
pH
The aqueous solution (1%) of lipogel was taken and measured pH value of it by using pH meter. Before measuring the pH of lipogel, the glass electrodes were calibrated with the help of buffer solution containing pH (4.00 and 9.00). Then, leave it for 15 min to attain the point of equilibrium. The observed the pH of herbal lipogel that was 6.257±0.002, it was completely acceptable by skin pH [79].
Extrudability, spreadability and viscosity
The gel was filled into a collapsible aluminum tube. Then, pressed the gel material to extrude out from the tube and 10g gel was filled into a collapsible tube and then held it between two clamps. Then, compressed the tube and determined the extrudability of the gel formulation by measuring the weight into gs required to extrude a gel ribbon of 0.5 cm in 10s. The extrudability of optimized herbal lipogel was found to be excellent [80, 81].
The spreadability of optimized herbal lipogel was found to be 15.655±0.002 (g/s), which is suitable for topical application and gives maximum absorption when applied on epidermis layer of skin. Its application is convenient and safe for acne patients [82].
The viscosity of prepared lipogel was measured using a Brookfield viscometer at 25 °C and rotated spindle at 2 rpm. The Viscometer was observed for rheological uses. The 30 mg sample was kept into a beaker and allowed to equilibrate before measuring the dial reading using L-4 spindle at 100 rpm for 5 min. At the speed, the simultaneous dial reading on the viscometer was observed. The spindle speed was correspondingly lowered, and the dial reading was noted. The observations were applied in triplicate. The viscosity of the optimized formulation was 2914.67± 31.33 cps that was also preferable range for acne patients. As we know, lesser the viscosity highest the rate of absorption on skin. On the basis of literature also, it was suitable value of viscosity for cure of acne patients [83].
Scanning electron microscopy (SEM)
Spherical and closed vesicles structure of liposome samples was observed as depicted in fig. 7(a) [84].
Transmission electron microscope (TEM)
The pictures of optimized liposomes viewed by TEM with uniform vesicular size as shown in fig. 7(b) [85].


Fig. 7: (a) SEM and (b) TEM of optimized herbal lipogel
Particle size of liposome-loaded hydrogels
Particle size of liposomes plays a vital role in stability, biological distribution, release profile and cellular uptake. Smaller the size of liposome particles, higher the area of the surface and there was a strong interaction between the components derived from agglomeration-aggregation. The size of optimized liposome vesicles was found to be 198 nm as shown in fig. 8(a).
Zeta potential (ZP) of liposome-loaded hydrogels
The zeta potential of an optimized formulation was found to be-19.8 mV as shown in fig. 8(b).


Fig. 8: (a) Particle size and (b) Zeta potential of optimized formulation C1F16
In vitro release studies
In vitro drug permeation studies were the main parameter for the observation of lipogel preparation in which drug particles were released from the lipo-carrier. By using a Franz diffusion cell, skin permeation studies of herbal extract were carried out. For in vitro drug release studies, cell membrane was used. It was experimented with phosphate buffer with pH 6.8, after 24 h and it was found to be 85.24 %. The in vitro drug release rate is shown in fig. 9.

Fig. 9: In vitro studies of optimized herbal lipogel formulation, extract of plant and herbal plain gel (n=3)
Drug release kinetic study
The release rate of liposomes was performed into phosphate buffer with pH 5.5 at constant temperature 37 °C for 100 rpm on a mechanical shaker. At different time intervals, 5 ml aliquots were withdrawn from receptor compartment and replaced equally with phosphate buffer pH 5.5 freshly prepared and analyzed on UV spectrometer immediately after carried out. To study the drug release kinetics, the in vitro drug release studies of different data with graph was plotted into various kinetic models: first order as log cumulative percentage of drug remaining Vs time, zero order as cumulative amount of drug releases Vs time, Higuchi model as cumulative percentage of drug released Vs square root of time. On the basis of drug release kinetics the values of R2 were determined. Formulation Code (C1F16) shows different drug release kinetics with R2 values of Zero order (0.904), First order (0.801), Higuchi (0.896) and Korseymeyer peppas (0.805). After finding the coefficient variables, Higuchi model found to fit into drug release kinetics data was the best. This demonstrates that herbal lipogel of extract of Ocimum tenuifloram plant was dispersed completely into the matrix of liposomes. It shows no interaction between the extract of plant and the liposome matrix. It also defines that the extract of plant was released from the liposome matrix by process of diffusion [86].
Anti-microbial studies
Bacterial strains of P. acne (MTCC No. 1951T) were procured from Institute of Microbial Technology, Chandigarh (India). This bacterial strain was maintained by agar slants using following standard guidelines [87].
ZOI
Prepared fresh suspension mixture into sterile water (Optical density: 0.6) into purchased P. acne sample cultures and mixed it with sterilized samples of dextrose agar and nutrient agar at 42.0±2.0 °C and kept them into a petridish until its solidification. Three wells of 6 mm diameter were bored into the medium by using a cork-borer 6 mm in diameter and properly labeled and 50,100µg/ml of extract, marketed formulation, lipogel with 25 µg/ml was filled into the walls by using micropipette. The same sets were designed for other samples. The petridish with a nutrient agar sample for microbial growth was cultured at 37±2.0 °C for two days with 24±2.0 °C temperature for five days. Then, observed the plates for ZOI studies. For the estimated study of antimicrobial substances, the diameter of the ZOI was measured, which was visualized in fig. 10(a, b).

Fig. 10: ZOI (in mm) of (a) market formulation and (b) optimized herbal lipogel
The mean zone of inhibition of optimized herbal lipogel at different concentrations (100, 50 and 25µg/ml) was 19.31 mm, 12.675 mm and no zone of inhibition was found. On the other hand, the mean ZOI of the marketed formulation at different concentrations (100, 50 and 25µg/ml) 16.212 mm, 10.287 mm and no zone of inhibition was found [88].
MIC test
By using thioglycollate broth, prepared 9 dilutions of different concentrations of extract for MIC studies. Into the initial tube, 380 µl of thioglycollate broth with 20 µl of extract was added. Then, 200 µl of thioglycollate broth for dilution was added to the 9 different tubes randomly. Then, a 200 µl sample from the initial tube was poured into the first tube with 200µl of thioglycollate broth, and it was considered into 10-1 dilution. From the sample of a 10-1 diluted tube, transferred 200µl into the second tube to make up the dilution of 10–2 volumes. Then, the process of dilution was repeated dilutions up to 10–9 dilutions for extracted samples. Then, 5 µl samples were poured into 2 ml of thioglycollate broth from the maintained stock cultures of required organisms. Into each sample of diluted tube 200 µl of suspension culture was added. Then, the sample tubes were incubated into an anaerobic jar for 48–72 h at 37 °C and recorded the results [89]. The mean of MIC studies at different concentrations (100, 50, 25, 12.5, 6.25, 3.12, 1.6, 0.8, 0.4, and 0.2 µg/ml) of plant extract was 1.33µg/ml and Herbal lipogel was 0.67µg/ml.
MBC test
The first 3 or 5 tubes were coated with the diluted samples and incubated for 24 h. On the other day, the colonies were counted. By observing MBC studies, we observed bacterial or bacteriostatic effects of extract samples against bacteria. If no growth was observed, it had a means negative bacterial effect on the sample. If any growth is observed, it means a bacteriostatic effect on bacteria. Tubes were incubated into anaerobic jars with strict anaerobes for the time of 48–72 h [90]. The mean of the studies at different concentrations (100, 50, 25, 12.5, 6.25, 3.12, 1.6, 0.8, 0.4 and 0.2 µg/ml) of plant extract was 1.33µg/ml and Herbal lipogel was 2.67µg/ml as shown in table 8.
Table 8: ZOI, MIC, MBC of optimized herbal lipogel with different concentration of extract (in mm) and Market formulation (in mm)
| ZOI (mm) | Mean | Conc. 100mcg/ml | Conc.50mcg/ml |
| Optimized formulation | 19.31 | 12.675 | |
| Market formulation | 16.212 | 10.287 | |
| MIC (µg/ml) | Optimized formulation | 1.33 | 0.46 |
| Market formulation | 0.67 | 0.23 | |
| MBC (µg/ml) | Optimized formulation | 2.67 | 0.92 |
| Market formulation | 1.33 | 0.46 |
The results showed that the extract of Ocimum tenuifloram gives strong anti-microbial activity against p. acne at 100µg/ml conc. and other sample with 50µg/ml conc. At higher conc., Ocimum tenuifloram methanolic extract shows strong anti-microbial activity, rather than marketed formulation. The MBC and MIC calculations of eugenol were observed against P. acne bacteria before and after encapsulation into liposome particles. It was proved that anti-bacterial activity of eugenol was upgraded after embodied into liposome layers. On the basis of ZOI, plant extract showed antibacterial activity against g+ve P. acne in a strong and medium way [91].
In vivo anti-acne studies
The anti-acne study was measured on the basis of parameters like redness with Skin irritation test and bacterial multiplication rate (CFU/ml). All Wistar rats were sacrificed after last treatment with in 24 h and the topical layer from the applied sites was removed and homogenized into a physiological saline solution. Then, a part of homogenate was stored and colonized on Blood Agar plates. The cultures grown on agar plates were observed to find out the number of CFU/ml after 1 to 4 d as shown in table 9 [92, 93]. The anti-acne in vivo studies on Wistar rats were performed after taking IAEC permission. The anti-acne effect of methanolic extract of Ocimum tenuifloram plant lipogel on Wistar rats was evaluated. The acne healing property of optimized herbal lipogel group was greater than control group. The group of Wistar rats with optimized herbal lipogel showed higher rate of acne-healing activity than standard marketed formulation. It was observed that all the groups than control showed decrease acne effect day by day.
The optimized herbal lipogel was spread on the outer layer of rat skin and observed the area for 3 d and note down skin irritation changes. No erythma and no irritation were observed on the skin of Wistar rat. So, it was concluded that the formulation was safe to use topically.
Table 9: Different groups of animals for in vivo studies (n=3)
| Sample identification | Group-1 No. of colonies (CFU/ml) herbal lipogel group | Group-2 No. of colonies (CFU/ml) marketed formulation | Group-3 No. of colonies (CFU/ml) plain gel | Group-4 No. of colonies (CFU/ml) control group |
| A | 180 | 450 | 760 | 82000 |
| B | 250 | 300 | 780 | 86000 |
| C | 170 | 350 | 800 | 81000 |
| D | 210 | 400 | 770 | 80000 |
| E | 260 | 380 | 760 | 84000 |
| F | 200 | 430 | 750 | 87000 |
| Mean | 212 | 385 | 770 | 83000 |
| Skin irritation test | No erythma and no irritation/redness | Low Erythma with redness | Erythma and irritation | Erythma, redness and irritation |
On the basis of results, it was concluded that the methanolic extract of Ocimum tenuifloram plant was safe on the skin of wistar rats and it contracts its ability of anti-acne on compared by standard herbal formulation of acne.
Stability studies
The reason behind stability studies was to observe the presence of plant constituents with time, consistent the range of a variety of atmospheric factors such as humidity, temperature and light. The results of stability studies were shown in table 10.
The pH values of lipogel were not changed significantly. The results of stability study on organoleptic properties (color, odor and visual appearance), pH, drug content, viscosity and spreadability for 6 Mo of herbal lipogel were shown in
fig. 11(a-e).





Fig. 11: Graphical representation of results of (a) pH, (b) spreadability, (c) drug content, (d) viscosity graph, (e) entrapment efficiency of optimized herbal lipogel for stability studies
Table 10: Effect of storage conditions on organoleptic properties of optimized herbal lipogel (n=3)
| Effect of storage on pH | ||||
| Time (Days) | Control (RT) | Refrigerator 4±2 °C | 25±2 °C | 40±2 °C |
| 0 d | 5.257±0.002 | 5.434±0.025 | 5.27±0.004 | 5.118±0.003 |
| 1 Mo | 5.254±0.004 | 5.418±0.003 | 5.261±0.003 | 5.121±0.003 |
| 3 Mo | 5.256±0.003 | 5.423±0.002 | 5.258±0.004 | 5.122±0.003 |
| 6 Mo | 5.223±0.002 | 5.43±0.003 | 5.253±0.004 | 5.111±0.004 |
| Effect of storage on viscosity | ||||
| 0 d | 29149±6.110 | 29169±3.464 | 29145±3.606 | 29133±4.726 |
| 1 Mo | 29145±7.000 | 29179±7.572 | 29148±6.506 | 29130±5.568 |
| 3 Mo | 29149±1.528 | 29194±4.359 | 29149±3.512 | 29131±4.726 |
| 6 Mo | 29145±2.517 | 29199±6.110 | 29147±3.055 | 29135±6.506 |
| Effect of storage on entrapment efficiency | ||||
| 0 d | 79.81±0.781 | 79.8±0.391 | 79.81±0.983 | 79.8±0.597 |
| 1 Mo | 79.8±0.597 | 79.81±0.597 | 79.8±1.626 | 79.8±1.033 |
| 3 Mo | 79.75±0.781 | 79.77±0.813 | 79.76±0.677 | 79.76±0.597 |
| 6 Mo | 79.73±0.813 | 79.75±0.781 | 79.74±0.983 | 79.76±0.597 |
Results observed that the gel had a smooth appearance and a sweet aromatic smell with brown color and had no lump formation in it.
No significant change was observed into organoleptic properties of formulation like pH, viscosity spreadability, entrapment efficiency. The result indicated that the gel was stable for six months. The entrapment efficiency was 79.8±0.15% found during stability studies. The range of pH after six months stability studies was nearby 5.25±2.5 and on another side the range of viscosity of optimized batch (C1F16) was nearby 29149 cps as shown in table 11.
Table 11: Effect of storage conditions on pH, viscosity and entrapment efficiency of optimized herbal lipogel (n=3)
| Effect of storage on pH | ||||
| Time (Days) | Control (RT) | Refrigerator 4±2 °C | 25±2 °C | 40±2 °C |
| 0 d | 6.257±0.002 | 6.434±0.025 | 6.27±0.004 | 6.118±0.003 |
| 1 Mo | 6.254±0.004 | 6.418±0.003 | 6.261±0.003 | 6.121±0.003 |
| 3 Mo | 6.256±0.003 | 6.423±0.002 | 6.258±0.004 | 6.122±0.003 |
| 6 Mo | 6.223±0.002 | 6.43±0.003 | 6.253±0.004 | 6.111±0.004 |
| Effect of storage on viscosity | ||||
| 0 d | 2919±6.110 | 2919±3.464 | 2915±3.606 | 2913±4.726 |
| 1 Mo | 2915±7.000 | 2919±7.572 | 2918±6.506 | 2910±5.568 |
| 3 Mo | 2919±1.528 | 2914±4.359 | 2919±3.512 | 2911±4.726 |
| 6 Mo | 2915±2.517 | 2919±6.110 | 2917±3.055 | 2915±6.506 |
| Effect of storage on entrapment efficiency | ||||
| 0 d | 79.81±0.781 | 79.8±0.391 | 79.81±0.983 | 79.8±0.597 |
| 1 Mo | 79.8±0.597 | 79.81±0.597 | 79.8±1.626 | 79.8±1.033 |
| 3 Mo | 79.75±0.781 | 79.77±0.813 | 79.76±0.677 | 79.76±0.597 |
| 6 Mo | 79.73±0.813 | 79.75±0.781 | 79.74±0.983 | 79.76±0.597 |
There was no specific effect of temperature and humidity on pH, viscosity and entrapment efficiency of optimized batch of herbal lipogel. Only minor changes in the data were observed within six months of stability studies. All values were expressed as mean±SD; n = 6 [94, 95].
This research work was designed to formulate herbal anti-acne lipogel by ethanol injection method based upon topical application with novel drug delivery system. Batch F16 formulation was found to be an optimized due has high value of entrapment efficiency with lesser size of particles and less than<-30mV zeta potential, that was suitable and stable for long time use as topical anti-acne preparation. The optimized batch of liposomes resulted into particle size with 198 nm. On the basis of literature study, it was found that less than 300 nm size, liposomes was suitable for topical and transdermal formulation. Formulation with lesser particle size shows high drug release rate and it becomes easy for small particles of liposomes to pass through skin layers. The observation of zeta potential revealed that prepared liposome were highly stable due to the charge present on the particles of liposome suspension being less than<-30mV that represent prepared herbal lipogel was highly stable and maximum shelf life on storage. The homogeneity and consistency of optimized batch of formulation was excellent. The lipophillic nature of eugenol limits its role in cosmetics formulation. So, it was hypothesized that its encapsulation into liposomes will affect its permeability role as liposomes, by reducing trans-epidermal loss of water and it increases smoothness by regenerated skin lipids lost. Additionally, the anti-acne activity of plant extract was observed by MIC, MBC and ZOI with lower concentration and higher concentration of plant extract. Test results of optimized formulation showed better anti-bacterial property than other standard formulations of acne. So, on the basis of results it was observed that all the groups showed decreasing rate of acne in 3-4 d. The extrudability, spreadability and visocity of optimized herbal lipogel were found to be excellent, 15.655±0.002 (g/s) and 2914.67±31.33 cps which was suitable for topical application in acne patients. In this research work, we only discussed and study about the anti-bacterial and anti-acne activity of eugenol found in plant extract. In this study, evaluation of in vitro and in vivo inhibitory potential of Ocimum tenuifloram (L.) extract was observed. Besides of this, the authors will also try to work hard on future research, such as testing on human subjects or exploring additional herbs with similar properties of anti-acne herbal products.
Authors are thankful to Microbial Technology, Chandigarh (India), Haryana Test House and Consultancy Services, Panipat (Haryana), Oniosome Healthcare Pvt. Ltd, Mohali (Punjab), Department of Microbiology, Belgaun (Tamil Nadu) for their support and cooperation to carry out the work. Authors also wish to thank the Head, Sophisticated Analytical Instrument Facility (SAIF) MDU, Rohtak for data analysis of our samples.
Nil
All experiments related to animal work were performed using the following International guidelines (US, 1989) and IPA by Animal Ethical Committee of CPCSEA, New Delhi approved by IEAC (Institutional Animal Ethics Committee) with registration number 1767/RES/14CPCSEA dated December 11, 2021. All efforts were made to minimize animal suffering and to reduce the number of animals used.
Vandana Singh: Writing-Original Draft Preparation, Conceptualization; Ravinder Verma: Software, Writing-Review and Editing, Data Curation; Vineet Mittal: Conceptualization, Supervision; Deepak Kaushik: Conceptualization, Supervision. All the authors have read and agreed to publish the manuscript.
Declared none
Nguyen R, Su J. Treatment of acne vulgaris. Paediatrics and Child Health. 2011 Mar 1;21(3):119-25. doi: 10.1016/j.paed.2010.09.012.
Prabu SL, Umamaheswari A, Rajakumar S, Bhuvaneswari P, Muthupetchi S. Development and evaluation of gel incorporated with synthesized silver nanoparticle from Ocimum gratissimum for the treatment of acne vulgaris. Am J Drug Deliv. 2017;5(3):107-17. doi: 10.21767/2321-547X.1000018.
Peng S, Zou L, Liu WE, Gan LU, Liu W, Liang R. Storage stability and antibacterial activity of eugenol nanoliposomes prepared by an ethanol injection dynamic high-pressure microfluidization method. J Food Prot. 2015 Jan 1;78(1):22-30. doi: 10.4315/0362-028X.JFP-14-246, PMID 25581174.
Viyoch J, Pisutthanan N, Faikreua A, Nupangta K, Wangtorpol K, Ngokkuen J. Evaluation of in vitro antimicrobial activity of thai basil oils and their micro-emulsion formulas against propionibacterium acnes. Int J Cosmet Sci. 2006 Apr;28(2):125-33. doi: 10.1111/j.1467-2494.2006.00308.x, PMID 18492147.
Magin PJ, Adams J, Pond CD, Smith W. Topical and oral CAM in acne: a review of the empirical evidence and a consideration of its context. Complement Ther Med. 2006 Mar 1;14(1):62-76. doi: 10.1016/j.ctim.2005.10.007, PMID 16473756.
Martin KW, Ernst E. Herbal medicines for treatment of bacterial infections: a review of controlled clinical trials. J Antimicrob Chemother. 2003 Feb 1;51(2):241-6. doi: 10.1093/jac/dkg087, PMID 12562687.
Orafidiya L. The effect of aloe vera gel on the anti-acne properties of the essential oil of Ocimum gratissimum Linn leaf a preliminary clinical investigation. Int J Aromather. 2004 Jan 1;14(1):15-21. doi: 10.1016/j.ijat.2003.12.005.
Kuver S, Palshikar G. Formulation and evaluation of herbal anti-acne face wash. Int J Phytother Res. 2014;4(2):1-9.
Jappe UT. Pathological mechanisms of acne with special emphasis on Propionibacterium acnes and related therapy. Acta Derm Venereol. 2003 Aug 21;83(4):241-8. doi: 10.1080/00015550310016463, PMID 12926793.
Amit Kumar AK, Anu Rahal AR, Sandip Chakraborty SC, Ruchi Tiwari RT, Latheef SK, Kuldeep Dhama KD. Ocimum sanctum (Tulsi): a miracle herb and boon to medical science a review. International Journal of Agronomy and Plant Production. 2013;4(7):1580-9.
Moghimipour E, Tafaghodi M, Balouchi A, Handali S. Formulation and in vitro evaluation of topical liposomal gel of triamcinolone acetonide. Res J Pharm Biol Chem Sci. 2013;4(1):101-7.
Singh V, Redhu R, Verma R, Mittal V, Kaushik D. Anti-acne treatment using nanotechnology based on novel drug delivery system and patents on acne formulations: a review. Recent Pat Nanotechnol. 2021 Dec 1;15(4):331-50. doi: 10.2174/1872210514999201209214011, PMID 33302844.
Singh V, Verma R, Kaushik D, Mittal V. Recent patents on phytoconstituents based formulations for the treatment of acne infection: a review. Recent Pat Anti-Infect Drug Discov. 2020 Aug 1;15(2):119-36. doi: 10.2174/1574891X15666200929150103, PMID 32990540.
Pollock B, Turner D, Stringer MR, Bojar RA, Goulden V, Stables GI. Topical aminolaevulinic acid photodynamic therapy for the treatment of acne vulgaris: a study of clinical efficacy and mechanism of action. Br J Dermatol. 2004 Sep 1;151(3):616-22. doi: 10.1111/j.1365-2133.2004.06110.x, PMID 15377348.
Fulton JR JE, Farzad Bakshandeh A, Bradley S. Studies on the mechanism of action to topical benzoyl peroxide and vitamin a acid in acne vulgaris. J Cutan Pathol. 1974 Oct;1(5):191-200. doi: 10.1111/j.1600-0560.1974.tb00628.x, PMID 4283462.
Cong TX, Hao D, Wen X, Li XH, He G, Jiang X. From pathogenesis of acne vulgaris to anti-acne agents. Arch Dermatol Res. 2019 Jul 5;311(5):337-49. doi: 10.1007/s00403-019-01908-x, PMID 30859308.
Poomanee W, Chaiyana W, Mueller M, Viernstein H, Khunkitti W, Leelapornpisid P. In vitro investigation of anti-acne properties of Mangifera indica L. kernel extract and its mechanism of action against propionibacterium acnes. Anaerobe. 2018 Aug 1;52:64-74. doi: 10.1016/j.anaerobe.2018.05.004, PMID 29906773.
Dreno B. What is new in the pathophysiology of acne an overview. J Eur Acad Dermatol Venereol. 2017 Sep;31 Suppl 5:8-12. doi: 10.1111/jdv.14374, PMID 28805938.
Alharbi WS, Hosny KM. Development and optimization of ocular in situ gels loaded with ciprofloxacin cubic liquid crystalline nanoparticles. J Drug Deliv Sci Technol. 2020 Jun 1;57:101710. doi: 10.1016/j.jddst.2020.101710.
Hosny KM. Nanosized cubosomal thermogelling dispersion loaded with saquinavir mesylate to improve its bioavailability: preparation optimization in vitro and in vivo evaluation. Int J Nanomedicine. 2020 Jul 16;15:5113-29. doi: 10.2147/IJN.S261855, PMID 32764940.
Srivastav R, Pathak V, Tripathi P, Prasad I. Comparative phytochemical and physicochemical study of tulsi (Ocimum sanctum) and haldi (Curcuma longa). Int J Pharm Biol Arch. 2018 Mar 15;9(1):55-7.
Domlur Thyagaraj VD, Koshy R, Kachroo M, Mayachari AS, Sawant LP, Balasubramanium M. A validated RP-HPLC-UV/DAD method for simultaneous quantitative determination of rosmarinic acid and eugenol in Ocimum sanctum L. Pharm Methods. 2013 May 1;4(1):1-5. doi: 10.1016/j.phme.2013.08.003.
Prabu SL, Umamaheswari A, Rajakumar S, Bhuvaneswari P, Muthupetchi S. Development and evaluation of gel incorporated with synthesized silver nanoparticle from Ocimum gratissimum for the treatment of acne vulgaris. Am J Adv Drug Deliv. 2017;5(3):107-17. doi: 10.21767/2321-547X.1000018.
Bhuvaneshwari K, Gokulanathan A, Jayanthi M, Govindasamy V, Milella L, Lee S. Can Ocimum basilicum L. and Ocimum tenuiflorum L. in vitro culture be a potential source of secondary metabolites? Food Chem. 2016 Mar 1;194:55-60. doi: 10.1016/j.foodchem.2015.07.136, PMID 26471526.
Alam P, Gupta J, Firdouse S, Firdouse A. Afshan J. HPTLC method for qualitative and quantitative estimation of eugenol from Ocimum sanctum linn in polyherbal formulation. Int J Comp Pharm. 2012;7:1-3.
Dev N, Das AK, Hossain MA, Rahman SM. Chemical compositions of different extracts of Ocimum basilicum leaves. J Sci Res. 2010;3(1):197-206. doi: 10.3329/jsr.v3i1.5409.
Narendra Kumar HK, Chandra Mohana N, Nuthan BR, Ramesha KP, Rakshith D, Geetha N. Phyto-mediated synthesis of zinc oxide nanoparticles using aqueous plant extract of Ocimum americanum and evaluation of its bioactivity. SN Appl Sci. 2019 Jun;1(6):1-9. doi: 10.1007/s42452-019-0671-5.
Verma R, Kaushik D. Design and optimization of candesartan loaded self-nanoemulsifying drug delivery system for improving its dissolution rate and pharmacodynamic potential. Drug Deliv. 2020 Jan 1;27(1):756-71. doi: 10.1080/10717544.2020.1760961, PMID 32397771.
Rahman SA, Abdelmalak NS, Badawi A, Elbayoumy T, Sabry N, El Ramly A. Tretinoin loaded liposomal formulations: from lab to comparative clinical study in acne patients. Drug Deliv. 2016 May 3;23(4):1184-93. doi: 10.3109/10717544.2015.1041578, PMID 26004128.
Sinha S, Thapa S, Singh S, Dutt R, Verma R, Pandey P. Development of biocompatible nanoparticles of tizanidine hydrochloride in orodispersible films: in vitro characterization ex vivo permeation and cytotoxic study on carcinoma cells. Curr Drug Deliv. 2022 Dec 1;19(10):1061-72. doi: 10.2174/1567201819666220321111338, PMID 35319369.
Chatwal GR. Instrumental methods of chemical analysis. Himalaya publishing house; 2022 Mar 10.
Chorachoo J, Amnuaikit T, Voravuthikunchai SP. Liposomal encapsulated rhodomyrtone: a novel antiacne drug. Evid Based Complement Alternat Med. 2013;2013(1):157635. doi: 10.1155/2013/157635, PMID 23762104.
Hassanzadeh Kiabi F, Negahdari B. Antinociceptive synergistic interaction between Achillea millefolium and Origanum vulgare L. extract encapsulated in liposome in rat. Artif Cells Nanomed Biotechnol. 2018 Jul 4;46(5):994-1000. doi: 10.1080/21691401.2017.1354303, PMID 28720004.
Patel RP, Patel H, Baria A. Formulation and evaluation. Int J Drug Deliv Technol. 2009;1:42-5.
Siyal FJ, Memon Z, Siddiqui RA, Aslam Z, Nisar U, Imad R. Eugenol and liposome-based nanocarriers loaded with eugenol protect against anxiolytic disorder via down-regulation of neurokinin-1 receptors in mice. Pak J Pharm Sci. 2020 Sep 3;33(5 Suppl):2275-84. PMID 33832901.
Nuchuchua O, Saesoo S, Sramala I, Puttipipatkhachorn S, Soottitantawat A, Ruktanonchai U. Physicochemical investigation and molecular modeling of cyclodextrin complexation mechanism with eugenol. Food Res Int. 2009 Oct 1;42(8):1178-85. doi: 10.1016/j.foodres.2009.06.006.
Sankar C, Muthukumar S, Arulkumaran G, Shalini S, Sundaraganapathy R, samuel S. Formulation and characterization of liposomes containing clindamycin and green tea for anti acne. Res J Pharm Technol. 2019;12(12):5977-84. doi: 10.5958/0974-360X.2019.01038.2.
Nand P, Drabu S, Gupta RK, Bhatnagar A, Ali R. In vitro and in vivo assessment of polyherbal topical gel formulation for the treatment of acne vulgaris. Int J Drug Deliv. 2012 Oct 1;4(4):434.
Dave V, Sharma S, Yadav RB, Agarwal U. Herbal liposome for the topical delivery of ketoconazole for the effective treatment of seborrheic dermatitis. Appl Nanosci. 2017 Nov;7(8):973-87. doi: 10.1007/s13204-017-0634-3.
Yamini K, Onesimus T. Preparation and evaluation of herbal anti-acne gel. Int J Pharm Biol Sci. 2013 Aug 28;4(2):956-60.
Kim JY, Song JY, Lee EJ, Park SK. Rheological properties and microstructures of carbopol gel network system. Colloid Polym Sci. 2003 Jul;281(7):614-23. doi: 10.1007/s00396-002-0808-7.
Baranauskaite J, Duman G, Corapcıoglu G, Baranauskas A, Taralp A, Ivanauskas L. Liposomal incorporation to improve dissolution and stability of rosmarinic acid and carvacrol extracted from oregano (O. onites L.). BioMed Res Int. 2018;2018(1):6147315. doi: 10.1155/2018/6147315, PMID 30140697.
Hasan M, Belhaj N, Benachour H, Barberi Heyob M, Kahn CJ, Jabbari E. Liposome encapsulation of curcumin: physico-chemical characterizations and effects on MCF7 cancer cell proliferation. Int J Pharm. 2014 Jan 30;461(1-2):519-28. doi: 10.1016/j.ijpharm.2013.12.007, PMID 24355620.
Fahmy AM, Hassan M, El Setouhy DA, Tayel SA, Al Mahallawi AM. Statistical optimization of hyaluronic acid enriched ultra deformable elastosomes for ocular delivery of voriconazole via box-Behnken design: in vitro characterization and in vivo evaluation. Drug Deliv. 2021 Jan 1;28(1):77-86. doi: 10.1080/10717544.2020.1858997, PMID 33342315.
Ahmad A, Abuzinadah MF, Alkreathy HM, Banaganapalli B, Mujeeb M. Ursolic acid rich Ocimum sanctum L. leaf extract loaded nanostructured lipid carriers ameliorate adjuvant-induced arthritis in rats by inhibition of COX-1, COX-2, TNF-α and IL-1: pharmacological and docking studies. PLOS One. 2018 Mar 20;13(3):e0193451. doi: 10.1371/journal.pone.0193451, PMID 29558494.
Gupta DR. Physico-chemical properties and quantum chemical calculation of 2-methoxy-4-(prop-2-en-1-yl) phenol (Eugenol). IJSRST. 2021;8(5):1-22. doi: 10.32628/IJSRST2184109.
Sondhi S, Singh N, Goyal K, Jindal S. Development of topical herbal gel of berberine hydrochloride for the treatment of psoriasis. Res J Pharm Form Tech. 2021;13(1):12-8. doi: 10.5958/0975-4377.2021.00003.3.
Aisha AF, Majid AM, Ismail Z. Preparation and characterization of nanoliposomes of Orthosipon stamineus ethanolic extract in soybean phospholipids. BMC Biotechnol. 2014 Dec;14(23):1. doi: 10.1186/1472-6750-14-23.
Mohammed WH, Ali WK, Al Awady MJ. Evaluation of in vitro drug release kinetics and antibacterial activity of vancomycin HCl-loaded nanogel for topical application. J Pharm Sci Res. 2018 Nov 1;10(11):2747-56.
Huh AJ, Kwon YJ. Nanoantibiotics: a new paradigm for treating infectious diseases using nanomaterials in the antibiotics resistant era. J Control Release. 2011 Dec 10;156(2):128-45. doi: 10.1016/j.jconrel.2011.07.002, PMID 21763369.
Budiman A, Rusnawan DW, Yuliana A. Antibacterial activity of Piper betle L. extract in cream dosage forms against staphylococcus aureus and propionibacterium acne. J Pharm Sci Res. 2018 Mar 1;10(3):493-6.
Saviuc C, Ciubuca B, Dinca G, Bleotu C, Drumea V, Chifiriuc MC. Development and sequential analysis of a new multi-agent anti-acne formulation based on plant-derived antimicrobial and anti-inflammatory compounds. Int J Mol Sci. 2017 Jan 17;18(1):175. doi: 10.3390/ijms18010175, PMID 28106736.
CLSI W. Clinical and laboratory standards institute methods for dilution antimicrobial susceptibility tests for bacteria that grow aerobically. In: approve standard. 7th ed. Pennysylvania, United States. Clinical and Laboratory Standards Institute; 2006. p. M7, A7.
Taleb MH, Abdeltawab NF, Shamma RN, Abdelgayed SS, Mohamed SS, Farag MA. Origanum vulgare L. essential oil as a potential anti-acne topical nanoemulsion in vitro and in vivo study. Molecules. 2018 Aug 28;23(9):2164. doi: 10.3390/molecules23092164, PMID 30154336.
Sawarkar HA, Khadabadi SS, Mankar DM, Farooqui IA, Jagtap NS. Development and biological evaluation of herbal anti-acne gel. Int J PharmTech Res. 2010 Jul;2(3):2028-31.
Aruna MS, Sravani A, Resshma V, Priya NS, Prabha MS, Rao NR. Formulation and evaluation of herbal acne gel. World J Pharm Res. 2015 Mar 14;4(5):2324-30.
Madan S, Nehate C, Barman TK, Rathore AS, Koul V. Design preparation and evaluation of liposomal gel formulations for the treatment of acne: in vitro and in vivo studies. Drug Dev Ind Pharm. 2019 Mar 4;45(3):395-404. doi: 10.1080/03639045.2018.1546310, PMID 30442066.
Shamma RN, Salah Ad din I, Abdeltawab NF. Dapsone gel as a novel platform for acne treatment: in vitro evaluation and in vivo performance and histopathological studies in acne infected mice. J Drug Deliv Sci Technol. 2019;54:101238. doi: 10.1016/j.jddst.2019.101238.
Ellaithy HM, El-Shaboury KM. The development of cutina lipogels and gel microemulsion for topical administration of fluconazole. AAPS PharmSciTech. 2002 Feb;3(4):77-85. doi: 10.1208/pt030435.
Inam F, Deo SU, Narkhede NE. HPLC–UV method development and quantification of eugenol from methanolic extracts of some spices. Int J Chem Physiol Sci. 2014 Nov;3(6):92-102.
Nargis Khan NK, Ali SA. Quantitative determination of eugenol in aqueous extract of Ocimum sanctum by high-performance thin layer chromatography. Journal of Pharmacy Research. 2014;8(8):1158-61.
Asili J, Mosallaei N, Shaterzadeh A, Malaekeh NB. Preparation and characterization of liposomes containing methanol extract of aerial parts of Platycladus orientalis (L.) Franco. 2012;2(1):17-23. doi: 10.22038/AJP.2011.24.
Dighe VV, Charegaonkar GA. HPTLC quantitation of eugenol from leaf and berry powder of Pimenta dioica (L.) merr. Anal Chem. 2009:8(1):29-33.
Sundaram RS, Ramanathan M, Rajesh R, Satheesh B, Saravanan D. LC-MS quantification of rosmarinic acid and ursolic acid in the Ocimum sanctum Linn. Journal of Liquid Chromatography & Related Technologies. 2012 Mar 1;35(5):634-50. doi: 10.1080/10826076.2011.606583.
Itankar PR, Tauqeer M, Dalal JS, Chatole PG. Simultaneous determination of ursolic acid and eugenol from Ocimum sanctum L. cultivated by organic and non-organic farming. Indian Journal of Traditional Knowledge. 2015 Oct;14(4):620-5.
Sundaram RS, Ramanathan M, Rajesh R, Satheesh B, Saravanan D. LC-MS quantification of rosmarinic acid and ursolic acid in the Ocimum sanctum Linn. leaf extract (Holy basil, Tulsi). J Liq Chrom Technol. 2012 Mar 1;35(5):634-50. doi: 10.1080/10826076.2011.606583.
Hathout RM, Mansour S, Mortada ND, Guinedi AS. Liposomes as an ocular delivery system for acetazolamide: in vitro and in vivo studies. AAPS PharmSciTech. 2007;8(1):1. doi: 10.1208/pt0801001, PMID 17408209.
Arora S, Rajwade JM, Paknikar KM. Nanotoxicology and in vitro studies: the need of the hour. Toxicol Appl Pharmacol. 2012 Jan 15;258(2):151-65. doi: 10.1016/j.taap.2011.11.010, PMID 22178382.
Shao M, Hussain Z, Thu HE, Khan S, Katas H, Ahmed TA. Drug nanocarrier the future of atopic diseases: advanced drug delivery systems and smart management of disease. Colloids Surf B Biointerfaces. 2016 Nov 1;147:475-91. doi: 10.1016/j.colsurfb.2016.08.027, PMID 27592075.
Hosny KM, Rizg WY. Quality by design approach to optimize the formulation variables influencing the characteristics of biodegradable intramuscular in-situ gel loaded with alendronate sodium for osteoporosis. PLOS One. 2018 Jun 1;13(6):e0197540. doi: 10.1371/journal.pone.0197540, PMID 29856752.
Lai C, Li C, Liu M, Qiu Q, Luo X, Liu X. Effect of kupffer cells depletion on abc phenomenon induced by kupffer cells-targeted liposomes. Asian J Pharm Sci. 2019 Jul 1;14(4):455-64. doi: 10.1016/j.ajps.2018.07.004, PMID 32104474.
Kassem AA, Abd El Alim SH. Vesicular nanocarriers: a potential platform for dermal and transdermal drug delivery. In: Yata VK, Ranjan S, Dasgupta N, Lichtfouse E. editors. Nanopharmaceuticals: Principles and Applications Cham: Springer International Publishing; 2021. p. 155-209. doi: 10.1007/978-3-030-44921-6_5.
Hanifah M, Jufri M. Formulation and stability testing of nanoemulsion lotion containing Centella asiatica extract. J Young Pharm. 2018;10(4):404-8. doi: 10.5530/jyp.2018.10.89.
Salem HF, Kharshoum RM, Awad SM, Ahmed Mostafa M, Abou Taleb HA. Tailoring of retinyl palmitate based ethosomal hydrogel as a novel nanoplatform for acne vulgaris management: fabrication optimization and clinical evaluation employing a split face comparative study. Int J Nanomedicine. 2021 Jun 24;16:4251-76. doi: 10.2147/IJN.S301597, PMID 34211271.
Munin A, Edwards Levy F. Encapsulation of natural polyphenolic compounds; a review. Pharmaceutics. 2011 Nov 4;3(4):793-829. doi: 10.3390/pharmaceutics3040793, PMID 24309309.
Ramesh V, Kumar KA. Herbally medicated liposomal gel for acne vulgaris. World J Pharm Res. 2017 Sep 9;6(14):507-29. doi: 10.20959/wjpr201714-9917.
Kamra M. Novel topical liposomal gel of benzoyl peroxide and resveratrol for treatment of acne. AJPRD. 2018;6(2):27-42. doi: 10.22270/ajprd.v6i2.362.
Hosadurga RR, Rao SN, Edavanputhalath R, Jose J, Rompicharla NC, Shakil M. Evaluation of the efficacy of 2% Ocimum sanctum gel in the treatment of experimental periodontitis. Int J Pharm Investig. 2015 Jan;5(1):35-42. doi: 10.4103/2230-973X.147231, PMID 25599031.
Shah A, Boldhane S, Pawar A, Bothiraja C. Advanced development of a non-ionic surfactant and cholesterol material-based niosomal gel formulation for the topical delivery of anti-acne drugs. Mater Adv. 2020;1(6):1763-74. doi: 10.1039/D0MA00298D.
Gallardo V, Muñoz M, Ruiz MA. Formulations of hydrogels and lipogels with vitamin E. J Cosmet Dermatol. 2005 Sep;4(3):187-92. doi: 10.1111/j.1473-2165.2005.00310.x, PMID 17129265.
Panigrahi L, Ghosal SK, Pattnaik S, Maharana L, Barik BB. Effect of permeation enhancers on the release and permeation kinetics of lincomycin hydrochloride gel formulations through mouse skin. Indian J Pharm Sci. 2006 Mar 1;68(2):205. doi: 10.4103/0250-474X.25716.
Vijayalakshmi A, Tripura A, Ravichandiran V. Development and evaluation of anti-acne products from Terminalia arjuna bark. Int J ChemTech Res. 2011 Jan;3(1):320-7.
Bachhav YG, Patravale VB. Microemulsion based vaginal gel of fluconazole: formulation in vitro and in vivo evaluation. Int J Pharm. 2009 Jan 5;365(1-2):175-9. doi: 10.1016/j.ijpharm.2008.08.021, PMID 18790032.
Aguilar Perez KM, Medina DI, Narayanan J, Parra Saldivar R, Iqbal HM. Synthesis and nano-sized characterization of bioactive oregano essential oil molecule loaded small unilamellar nanoliposomes with antifungal potentialities. Molecules. 2021 May 13;26(10):2880. doi: 10.3390/molecules26102880, PMID 34068039.
Kuznetcova DV, Linder M, Jeandel C, Paris C, Desor F, Baranenko DA. Nanoliposomes and nanoemulsions based on chia seed lipids: preparation and characterization. Int J Mol Sci. 2020 Nov 29;21(23):9079. doi: 10.3390/ijms21239079, PMID 33260309.
Gharib R, Auezova L, Charcosset C, Greige Gerges H. Drug in cyclodextrin in liposomes as a carrier system for volatile essential oil components: application to anethole. Food Chem. 2017 Mar 1;218:365-71. doi: 10.1016/j.foodchem.2016.09.110, PMID 27719922.
Pornpattananangkul D, Fu V, Thamphiwatana S, Zhang L, Chen M, Vecchio J. In vivo treatment of Propionibacterium acnes infection with liposomal lauric acids. Adv Healthc Mater. 2013 Oct;2(10):1322-8. doi: 10.1002/adhm.201300002, PMID 23495239.
Naik LS, Shyam P, Marx KP, Baskari S, Devi VR. Antimicrobial activity and phytochemical analysis of Ocimum tenuiflorum leaf extract. Int J PharmTech Res. 2015 Jun 24;8(1):88-95.
Singh AR, Bajaj VK, Sekhawat PS, Singh K. Phytochemical estimation and antimicrobial activity of aqueous and methanolic extract of Ocimum sa+nctum L. J Nat Prod Plant Resour. 2013 Mar 20;3(1):51-8.
Hosny KM, Al Nahyah KS, Alhakamy NA. Self-nanoemulsion loaded with a combination of isotretinoin an anti-acne drug and quercetin: preparation optimization and in vivo assessment. Pharmaceutics. 2020 Dec 30;13(1):46. doi: 10.3390/pharmaceutics13010046, PMID 33396942.
Budhiraja A, Dhingra G. Development and characterization of a novel antiacne niosomal gel of rosmarinic acid. Drug Deliv. 2015 Aug 18;22(6):723-30. doi: 10.3109/10717544.2014.903010, PMID 24786487.
Baranauskaite J, Duman G, Corapcıoglu G, Baranauskas A, Taralp A, Ivanauskas L. Liposomal incorporation to improve dissolution and stability of rosmarinic acid and carvacrol extracted from oregano (O. onites L.). BioMed Res Int. 2018;2018(1):6147315. doi: 10.1155/2018/6147315, PMID 30140697.
Ellaithy HM, El Shaboury KM. The development of Cutina lipogels and gel microemulsion for topical administration of fluconazole. AAPS PharmSciTech. 2002 Feb;3(4):77-85. doi: 10.1208/pt030435.
Shahi S, Athawale RB. Development and evaluation of cosmeceutical Nanolipogel. Res J Top Cosmet Sci. 2010;1(1):18-24.
Talaat SM, Elnaggar YS, Abdalla OY. Lecithin microemulsion lipogels versus conventional gels for skin targeting of terconazole: in vitro ex vivo and in vivo investigation. AAPS PharmSciTech. 2019;20(4):161. doi: 10.1208/s12249-019-1374-3, PMID 30969396.